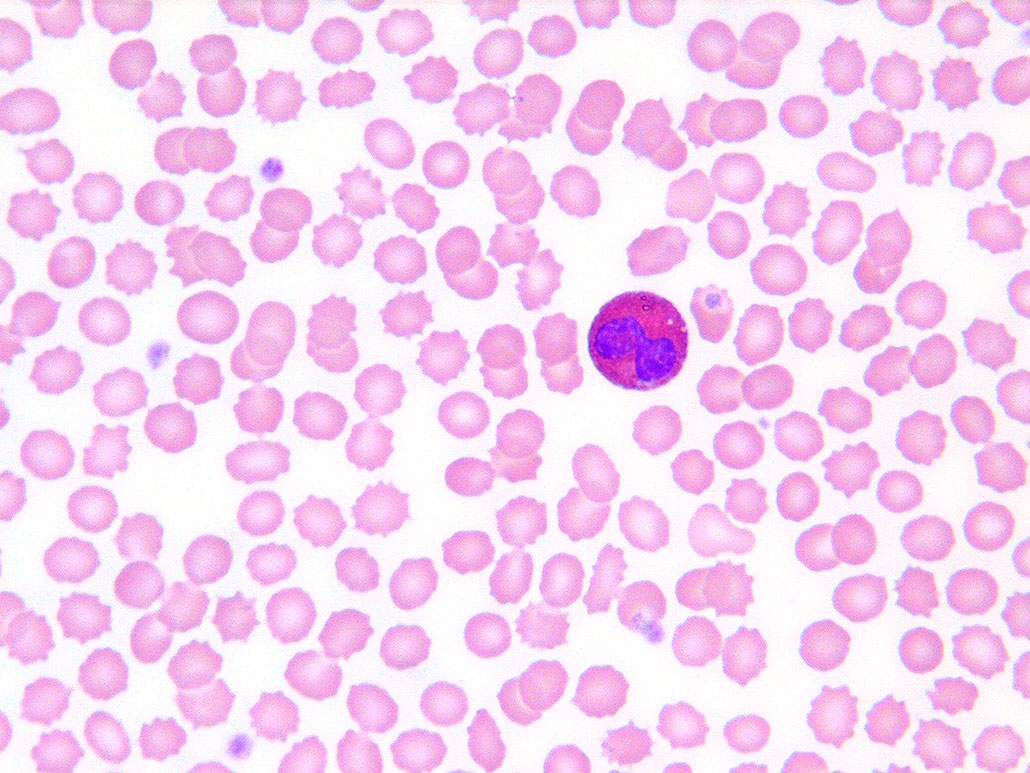
a microscopic image of blood cells, splotchy red blobs and an eosinophil,

Explainer: What is asthma and how is it treated?
Drugs can reduce this chronic narrowing of lung airways that can make breathing difficult
Exercise, pollution and other exposures can trigger asthma attacks, making it hard to breathe. Many people use inhalers (as here) to relax their airways again. Special shots are also available to help treat especially severe asthma symptoms.
Westend61/Westend61/Getty Images
Share this:
- Share via email (Opens in new window) Email
- Click to share on Facebook (Opens in new window) Facebook
- Click to share on X (Opens in new window) X
- Click to share on Pinterest (Opens in new window) Pinterest
- Click to share on Reddit (Opens in new window) Reddit
- Share to Google Classroom (Opens in new window) Google Classroom
- Click to print (Opens in new window) Print
By Sejal Parekh
Julianna Hayes is a 10-year-old who lives in New Hampshire. She has a black belt in karate, loves the ice cream flavor “tornado” and wants to be a teacher. She also has asthma.

This chronic lung condition can make it hard to breathe. People with asthma may feel fine most of the time. But if they encounter a trigger — such as smoke or animal fur —an attack may come on. During such an attack, people often cough, wheeze and feel tired.
Most of the time, Julianna says, “I feel like I imagine any other person without asthma would feel.” But sometimes during an asthma attack “my chest will get tight and I can’t breathe in all the way.”
Luckily, Julianna has not had such an attack in a while. “I feel relieved that I’ve been diagnosed and that I have the right medication,” she says.
More than 26 million people in the United States — roughly one in every 13 — have asthma. Some may treat their condition with inhalers. Others may need newer medications, such as monthly shots. The good news: Having asthma does not need to stop you from doing what you want. With proper treatments, people with asthma can live normal lives.
Hard to breathe
Asthma affects how air moves through the lungs.
When you inhale, air flows from your mouth or nose through your windpipe and into your lungs. The windpipe is a bit like the trunk of a tree that splits into two branches, one leading to each lung. Within the lungs, these big branches split off into smaller and smaller branches.
At the ends of the tiniest branches, where a tree’s leaves would be, your lungs have small air sacs. The walls of these balloon-like sacs are only one cell wide! Here, your blood sucks up oxygen from the air.
Robyn Cohen is a doctor at Boston Medical Center in Massachusetts. She treats children with lung diseases. In someone with asthma, “the breathing tubes basically get swollen so that the tunnel inside the tube is narrowed,” she explains. That makes it harder to pull air into the lungs.
To make matters worse, some things can trigger small muscles around the outside of the airways to tighten. This squeezes the branches, narrowing the air space inside them even more.
This sudden constriction causes an asthma attack. Triggers can include pollutants and other things in the environment, such as pet dander (flaked off bits of skin). Viruses that cause colds also can trigger attacks. Sometimes, even exercise can bring on an attack.
Different people may have different triggers. Often, avoiding triggers is the best way to avoid an asthma attack. But it can be hard to avoid triggers like tree pollen or polluting gases (such as ozone) in the air.

An overactive immune system
The airway swelling in many people with asthma comes from an overactive immune system.
Our immune system is like a large army of blood cells that protect the body. Some of those cells are general soldiers. Others work as snipers with specific targets. Still others act more like lookouts. They warn the rest of the army of incoming threats.
Eosinophils (Ee-oh-SIN-uh-fils) are one type of lookout cell. In the lungs, eosinophils can send messages to recruit other immune cells to fight threats. But in some people with asthma, they work too aggressively. If overactive, they can recruit too many soldiers to the lungs. This can cause the airways to narrow.
Fortunately, narrow airways can be treated with asthma inhalers. These devices disperse medicine into the throat — usually as a very fine powder. As you inhale, this fine powder gets drawn into the smallest branches of the lungs. There, it can widen airways by relaxing muscles surrounding the lungs’ branching tunnels.
Inhalers can come in all different shapes and strengths of medication. “Not everybody needs medication every day,” says Cohen. “Some people only need it sometimes.”
However, traditional inhalers may not be enough for people with severe asthma.
To help these people, scientists have developed injectable medications over the past two decades. These shots are being prescribed to a small, but growing, number of people. Called biologics, these treatments work in a different way than the drugs in asthma inhalers. Instead of relaxing muscles, they act directly on the immune cells that trigger swelling.
Biologics get their name from the fact that they are not simple lab-made chemicals. Instead, they are large molecules, such as proteins, produced by living organisms. Some can even be whole genes.
Do you have a science question? We can help!
Submit your question here, and we might answer it an upcoming issue of Science News Explores
Some biologics for asthma treat overactive eosinophils. They keep those cells from signaling other immune cells. Another biologic prevents target cells from receiving the eosinophils’ signals. In each case, these therapies reduce how many immune cells move into the lungs. And fewer immune cells mean less swelling and easier breathing.
Biologics can help prevent frequent asthma attacks, notes Khalilah Gates. She’s a lung doctor at Northwestern Medicine in Chicago, Ill. People receiving biologics won’t need to use an inhaler as much (though they may still need one from time to time).
Biologics won’t help everyone with severe asthma. “Most of the biologics require a certain amount of eosinophils in the blood,” says Gates. So, doctors may do a blood test to check for levels of these before prescribing biologics. But, she says, “biologics have really been helpful in a subset of people.”
Medications matter
Biologics helped one of Cohen’s young patients with severe asthma. For years, this patient “could not go to the park, could not go to the playground and run around at all,” she says. He ended up in the hospital multiple times a year.
Once he started using a biologic, he didn’t have to go to the hospital. He even stopped missing school days because of his asthma, Cohen says.
One downside is that biologics have to be given as a shot. They can’t be given as a pill or inhaler. Most people get the shots once a month, though some must be given more frequently.
In 2025, it is “so exciting to be able to give really good asthma treatment for people, even if their asthma is severe,” Cohen says.
Julianna says her asthma doesn’t keep her from doing most things. The reason: She has the right medications and knows how to use them. “I feel like as long as you are diagnosed and you have what you need, it doesn’t stop you,” she says.